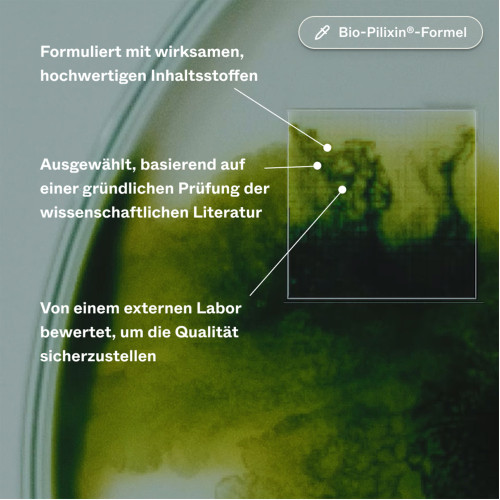
Hair Growth-Routine I Für Männer Set, 1 Pck., Scandinavian Biolabs ApS

- Medikamente bis zu 70% günstiger kaufen
- Schnell und unverbindlich Preise vergleichen
- Tiefpreisgarantie bei 180 Versandapotheken
Günstigste Gesamtbestellung
verschiedener Produkte
Sie benötigen verschiedene Produkte? Der Merkzettel vergleicht den Gesamtpreis aller Produkte und berechnet den günstigsten Anbieter.
Hair Growth-Routine I Für Männer Set
- rezeptfrei
- PZN: 17862504
- Klinisch getestet mit Ergebnissen nach 45 Tagen
- Reduziert Haarausfall und fördert neues Wachstum
- Auf die tägliche Pflege abgestimmt
-
Weitere
SANICARE Gutschein
* Geben Sie einfach bei Ihrer Bestellung ab € Ihren Gutschein-Code an. Gilt nur für rezeptfreie Produkte (außer Bücher). Gutschein ist nicht mit anderen Geschenken oder Aktionen kombinierbar. Nur einmalig & nicht rückwirkend einlösbar. Keine Barauszahlung möglich. Nur online einlösbar bis 31.12.2026.
Preisvergleich
-
63,32 €Zum Shop
Zahlungsarten-Details
 apolux.de
apolux.de
-
Vorkasse wird angeboten
-
Lastschrift wird angeboten
-
Kreditkarte wird angeboten
MasterCard, Visa, American Express -
Visa wird angeboten
-
American Express wird angeboten
-
MasterCard wird angeboten
-
PayPal wird angeboten
-
Rechnung (Klarna) wird angeboten
-
Amazon Payments wird angeboten
-
Apple Pay wird angeboten
Lieferzeit: sofort lieferbar- DHL
- DHL-Packstation
- HERMES
versandkostenfrei
Günstigster Gesamtpreis
63,32 € inkl. Versandapolux bietet viele Produkte auf medizinfuchs zu Sonderpreisen an. Diese Sonderpreise sind nur online gültig und auch nur, wenn Sie über die Medizinfuchs-Seite zum apolux.de Shop gehen. Grundpreis: 63,32 € / 1 Pck.Daten vom 11.05.26 15:47 2 -
-
63,33 €Zum Shop
Zahlungsarten-Details
 apodiscounter
apodiscounter
-
Vorkasse wird angeboten
-
Lastschrift wird angeboten
-
Kreditkarte wird angeboten
-
Visa wird angeboten
-
American Express wird angeboten
-
MasterCard wird angeboten
-
PayPal wird angeboten
-
PayPal Express wird angeboten
-
Rechnung wird angeboten
-
Rechnung (Klarna) wird angeboten
-
Klarna Sofortüberweisung wird angeboten
-
Amazon Payments wird angeboten
-
Klarna Ratenkauf wird angeboten
-
Klarna Lastschrift wird angeboten
Lieferzeit:- DHL
- DHL-Packstation
- HERMES
versandkostenfrei
Gesamtpreis: 63,33 €apo-discounter bietet viele Produkte auf medizinfuchs zu Sonderpreisen an. Diese Sonderpreise sind nur online gültig und auch nur, wenn Sie über die Medizinfuchs-Seite zum apo-discounter.de Shop gehen. Grundpreis: 63,33 € / 1 Pck.Daten vom 18.05.26 11:16 2 -
-
63,33 €Zum Shop
Zahlungsarten-Details
 juvalis.de
juvalis.de
-
Vorkasse wird angeboten
-
Lastschrift wird angeboten
-
Kreditkarte wird angeboten
-
Visa wird angeboten
-
American Express wird angeboten
-
MasterCard wird angeboten
-
PayPal wird angeboten
-
Rechnung (Klarna) wird angeboten
-
Amazon Payments wird angeboten
Lieferzeit: sofort lieferbar- DHL
- DHL-Packstation
- HERMES
versandkostenfrei
Gesamtpreis: 63,33 €juvalis.de bietet viele Produkte auf medizinfuchs zu Sonderpreisen an. Diese Sonderpreise sind nur online gültig und auch nur, wenn Sie über die Medizinfuchs-Seite zum juvalis.de Shop gehen.
Es kann in Einzelfällen produktbezogene Mengenbegrenzungen geben, um die haushaltsübliche Abgabe für bestimmte Arzneimittelgruppen mit Gefahrenpotential zu gewährleisten.Grundpreis: 63,33 € / 1 Pck.Daten vom 11.05.26 15:48 2 -
-
63,34 €Zum Shop
Zahlungsarten-Details
 Deutsche Internet Apotheke
Deutsche Internet Apotheke
-
Vorkasse wird angeboten
-
Lastschrift wird angeboten
-
Kreditkarte wird angeboten
-
Visa wird angeboten
-
American Express wird angeboten
-
MasterCard wird angeboten
-
PayPal wird angeboten
-
Rechnung (Klarna) wird angeboten
-
Amazon Payments wird angeboten
Lieferzeit: sofort lieferbar- DHL
- DHL-Packstation
- HERMES
versandkostenfrei
Gesamtpreis: 63,34 €Die "Deutsche Internet Apotheke" bietet viele Produkte auf medizinfuchs zu Sonderpreisen an. Diese Sonderpreise sind nur online gültig und auch nur, wenn Sie über die Medizinfuchs-Seite zum Shop der "Deutsche Internet Apotheke" gehen. Grundpreis: 63,34 € / 1 Pck.Daten vom 11.05.26 15:48 2 -
-
63,35 €Zum Shop
Zahlungsarten-Details
 apo.com
apo.com
-
Vorkasse wird angeboten
-
Lastschrift wird angeboten
-
Kreditkarte wird angeboten
-
Visa wird angeboten
-
American Express wird angeboten
-
MasterCard wird angeboten
-
PayPal wird angeboten
-
PayPal Express wird angeboten
-
Rechnung (Klarna) wird angeboten
-
Amazon Payments wird angeboten
Lieferzeit: sofort lieferbar- DHL
- DHL-Packstation
- HERMES
versandkostenfrei
Gesamtpreis: 63,35 €Gratis-Versand bei Bestellung mit Rezept Grundpreis: 63,35 € / 1 Pck.Daten vom 18.05.26 11:49 2 -
-
63,37 €Zum Shop
Zahlungsarten-Details
 wir leben • Apotheken
wir leben • Apotheken
-
Vorkasse wird angeboten
-
PayPal wird angeboten
-
Rechnung wird angeboten
ab 2 Bestellungen
+ Versand 4,25 €Gesamtpreis: 67,62 €Grundpreis: 63,37 € / 1 Pck.Daten vom 18.05.26 10:18 2 -
-
64,07 €Zum Shop
Zahlungsarten-Details
 mediherz.de
mediherz.de
-
Vorkasse wird angeboten
-
Lastschrift wird angeboten
Die Zahlung per Lastschrift ist bei Erstbestellern und Einmalbesteller (ohne Registrierung) nur bis zu einem Warenwert von 100,00 € möglich. -
Kreditkarte wird angeboten
-
Nachnahme wird angeboten
Gebühr: 5,90 € -
PayPal wird angeboten
-
Rechnung wird angeboten
Die Zahlung per Rechnung ist bei Erstbestellern und Einmalbesteller (ohne Registrierung) nur bis zu einem Warenwert von 100,00 € möglich. -
Klarna Sofortüberweisung wird angeboten
Lieferzeit: sofort lieferbar- DHL
- DHL-Packstation
versandkostenfrei
Gesamtpreis: 64,07 ۥ Schneller Versand aus Deutschland
• Bereits ab 19 EUR versandkostenfrei
• Gratis-Versand bei E-Rezept Bestellung über unsere APPGrundpreis: 64,07 € / 1 Pck.Daten vom 18.05.26 11:46 2 -
-
64,08 €Zum Shop
Zahlungsarten-Details
 docmorris.de
docmorris.de
-
Lastschrift wird angeboten
-
Kreditkarte wird angeboten
-
PayPal wird angeboten
-
Rechnung wird angeboten
-
Rechnung (Klarna) wird angeboten
-
Klarna Sofortüberweisung wird angeboten
Lieferzeit: sofort lieferbar- DHL
- DHL-Packstation
- HERMES
- trans-o-flex
- Thermomed
versandkostenfrei
Gesamtpreis: 64,08 €Bei Marktplatzpartnern gelten die Versandkosten des Drittanbieters, d.h. bei Bestellung verschiedener Produkte und Lieferung von mehreren Drittanbietern über docmorris.de können die Versandkosten höher sein. DocMorris bietet viele Produkte auf Medizinfuchs zu Sonderpreisen an. Diese Sonderpreise werden Ihnen nur berechnet, wenn Sie über die Medizinfuchs-Seite zum DocMorris-Shop gehen. Die Sonderpreise sind nicht mit anderen Vorteilscodes oder Gutscheinen kombinierbar. Bei Eingabe eines Vorteils- oder Gutscheincodes im Warenkorb von DocMorris kann daher ein höherer Preis berechnet werden. Grundpreis: 64,08 € / 1 Pck.Daten vom 18.05.26 11:47 2 -
Jetzt ein Konto erstellen, um Favoriten-Anbieter zu speichern
- Beliebig viele persönliche Merkzettel
- Ihre Bestellungen im Überblick
Sie haben bereits ein Konto?
Diese Einwilligung kann jederzeit auf www.medizinfuchs.de/newsletter-abmelden oder am Ende jeder E-Mail widerrufen werden.
Gibt die aktuelle durchschnittliche Lieferzeit in Werktagen nach einer Bestellung beim Anbieter an.
Die Angabe der Bestelldauer basiert auf den bei medizinfuchs abgegebenen Anbieter-Bewertungen zu Bestellungen, die innerhalb der letzten 4 Wochen erfolgt sind.
Newsletter
Melden Sie sich an und erhalten Sie noch mehr Rabatte, Gutscheine und Infos
Produktdetails & Pflichtangaben 3
Zu Risiken und Nebenwirkungen lesen Sie die Packungsbeilage und fragen Sie Ihre Ärztin, Ihren Arzt oder in Ihrer Apotheke.
Erfahrungsberichte zu Hair Growth-Routine I Für Männer Set, 1 Pck.
Die Produktbewertungen zu Hair Growth-Routine I Für Männer Set beinhalten die persönlichen Erfahrungen der Medizinfuchs-Nutzer. Sie dienen nicht als Ersatz für eine persönliche Beratung durch einen Arzt oder Apotheker.
Es sind noch keine Erfahrungsberichte vorhanden.
Helfen Sie anderen Nutzern und schreiben Sie einen Erfahrungsbericht!
Sitemap / Inhaltsverzeichnis
- Navigation
- Service
- Social Media
- Informationen